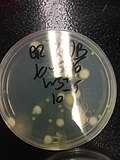

<nowiki>bacteria; Gerlar; Bakteria; bacteria; باکټريا; بیکٹیریا; بیکٹیریا; baktérie; Bactèri; 细菌; Bacteria; Bakteriyalar; Бактериялар; бактерија; Bakterije; बैक्टीरिया; Bateria; bactérie; bakterije; जीवाणू; ଜୀବାଣୁ; Bakterėjės; бактерија; Izinungwana; Bakterien; bakterier; baktéri; Bacteria; bakteriya; 細菌; bakteer; بكتيريا; Bakteri; ဘက်တီးရီးယား; 細菌; Бактериялар; Se-khiûn; bacteria; Bakterien; Бактериялар; bacteria; Bacteria; baictéar; باکتری; 细菌; Bakterier; ბაქტერიები; 細菌; bacterio; Kwayar cutar Bakteriya; Jisk'a laq'u; බැක්ටීරියා; bacterium; जीवाणुः; जीवाणु; 細菌; bakteerit; Bactereye; Bateri; Bacteria; باكتيرية; бактэрыі; бактерияләр; Bakterijad; แบคทีเรีย; Bakterija; Bacteria; Bateri; Бактерії; Βακτήριο; Bakteerien; Nemiltōpīllōtl; Bacteria; Baktearje; Bacteria; Sá̤-kṳ̄ng; Bakterya; Bagiteri; bacteris; bacterië; باکتری; бактерии; ബാക്റ്റീരിയ; bacterie; 细菌; bakterie; Bakteria; bakterier; bakteri; бактерії; Bakteri; Бактерия; Bacteria; ເຊື້ອແບັກທີເຣັຍ; 세균; Bakteria; bakterioj; Bakteriyalar; Bakteria; Batere; ব্যাকটেরিয়া; бактериос; baktèri; जीवाणु; ބެކްޓީރިޔާ; 细菌; baktērijas; באקטעריע; bacteria; Bakterije; bakteeros; bakterijos; ბაქტერიეფი; bakteria; bakterie; НӀанкӀигаш; Bakterie; Bactéria; 细菌; Нян; bakteriar; Bakter; Bbakitiiriya; Bakteri; Pisiläne; ಬ್ಯಾಕ್ಟೀರಿಯ; بەکتریا; bacteria; Eubacteria; Pokokaku'i; Bateria; bakterie; Bakteret; baktériumok; ባክቴሪያ; бактерии; илер; Vi khuẩn; bakterid; باکتری; Añaki; Baktiiria; Нян; бактэрыі; bakteri; Sigin; Bakterî; जीवाणु; Sè-khún; Batteriu; Bactéthie; 细菌; Baakteeriyaa(Bacteria); חיידקים; бактерияләр; Bacteria; bakteara; బాక్టీరియా; ܒܩܛܝܪܝܐ; Bakteriya; бактериялар; Bacterië; বেক্টেৰিয়া; Bacteria; Bacteria; Baktéri; Bakteri; 细菌; Bakterien; Бактерияр; բակտերիաներ; bakterio; Baktéríà; bakteeʹr; bactéria; batterji; ਜੀਵਾਣੂ; بكتيريا; ब्याक्टेरिया; bakterije; bacteria; Bakteeri; ᎥᏳᎩ ᏗᏱᏙᎯ; Bakterya; Bakteria; Bacteria; 细菌; Бактерисем; Бактериялар; بئڪٽيريا; பாக்டீரியா; bacteria; Bakterio; 细菌; Bakteria; ဘက္တီးရီးယား ( cocci); 原核生物嘅一域,係地球上最早出現嘅生命形式之一; egysejtű, többnyire pár mikrométeres mikroorganizmusok; microorganismu unicelular ensin clorofila; microorganismes; Reich bzw. Domäne der Lebewesen; po dheu; دامنهای از پروکاریوتها; империя микроорганизми; mikro-organisme sûnder kearn, ôfhinklik fan de soarte geunstich of skealik foar minsken; domeniu al microorganismelor; جراثیم; microorganismo procaryotic; encelliga mikroorganismer utan cellkärna och andra membranomslutna organeller; domain of micro-organisms; אורגניזמים חד-תאיים חסרי גרעין; 新壁总域的一域; 세균역을 구성하는 생물군; дамэн мікраарганізмаў; микро ағзалардың дуниесі; yksisoluisia mikroskooppisen pieniä eliöitä; এবিধ সৰল আৰু অতি ক্ষুদ্ৰ এককোষী জীৱ; sennukleaj unuĉelaj prokariotaj organismoj; doména jednobuněčných prokaryotních organismů; domain of prokaryotes; microrganismi unicellulari, procarioti; জীবসত্তা; organisme vivant unicellulaire et procaryote; домен прокариотических микроорганизмов; domena prokariotskih mikroorganizama; 分類学上のドメインの一つ; üherakulised eeltuumsed organismid; dakkel a grupo dagiti nabiag a prokaryote nga organismo; domene av prokaryote organismar; जीवाणु रोग; domain dari mikro-organisme; tipo de célula biológica; dominju ta' prokarjoti; microorganismo unicelular que presenta un tamaño de unos pocos micrómetros; domein van mikro-organismes; 原核生物的一种; isidlangala seziphilincinci; одна з основних груп живих організмів; domena prokariontov; khu vực của sinh vật nhân sơ; Domäne vun de Liewewiesen; domena organizmów bezjądrowych; domene av prokaryote organismer; domein van eencellige, soms in kolonies levende micro-organismen; ଏହା ଏକ ବିରାଟ ପ୍ରୋକାରିଓଟିକ ଅଣୁଜୀବମାନଙ୍କର ସମଷ୍ଟି ।; teyrnas o prokaryotes; 細菌者,簡稱菌,屬微生物,為單細胞之物,遍布天下,無處不有,數量之多,為生命之冠。菌之古,與天地同壽,四億年前已有其蹤,先於萬物而生,歷經千變萬化。; โดเมนของจุลินทรีย์; organismos unicelulares procariontes; كائنات وحيدة الخلية; προκαρυωτικός οργανισμός; mikroorganizma üst âlemi; Batteri; Eubatteri; Bacteria; bacteria; Bactéries; bakterija; бактерий; бактериәләр; eubacteri; Bacteris; Bacteria; Bactéria; batteri; یوباکتریا; Bacteria; eubacteria; evbakterije; cepljivke; 真性細菌; 真正細菌; バクテリア; Bacteria; бактэрыя; ยูแบคทีเรีย; บัคเตรี; Bacteria; Bacteria; bakterie; Bacteria; Eubacteria; бактериәләр; Bacteria; бактерия; eubacteria; Bacteria; 박테리아; باکتریا; بەكتریا; Bacteria; جرثوم; جرثومة; бактерии; baktērija</nowiki>
bacteria domain of micro-organisms  10.000× image video |
| Upload media |
|
| Instance of | |
|---|
| Subclass of | |
|---|
| Start time | - 3,501st millenniumBC (after 3,801st millenniumBC)
|
|---|
| Different from | |
|---|
|
|
| Taxon author | Carl Woese,2024 |
|---|
|
|
- Acidobacteria,Actinobacteria,Aquificae,Armatimonadetes,Bacteroidetes,Caldiserica,Chlamydiae,Chlorobi,Chloroflexi,Chrysiogenetes,Cyanobacteria,Deferribacteres,Deinococcus-Thermus,Dictyoglomi,Elusimicrobia,Fibrobacteres,Firmicutes,Fusobacteria,Gemmatimonadetes,Lentisphaerae,Nitrospirae,Planctomycetes,Proteobacteria,Spirochaetes,Synergistetes,Tenericutes,Thermodesulfobacteria,Thermotogae,Verrucomicrobia
- Acidobacteria,Actinobacteria,Aquificae,Bacteria incertae sedis,Bacteroidetes,Caldiserica,Chlamydiae,Chlorobi,Chloroflexi,Cyanobacteria,Deferribacteres,Deinococcus-Thermus,Elusimicrobia,Fibrobacteres,Firmicutes,Fusobacteria,Gemmatimonadetes,Lentisphaerae,Nitrospirae,Planctomycetes,Proteobacteria,Spirochaetes,Synergistetes,Tenericutes,Thermodesulfobacteria,Thermotogae,Verrucomicrobia
- Note: Only marine phyla
- Abditibacteriota,Acidobacteriota,Actinomycetota,Aquificota,Armatimonadota,Atribacterota,Bacillota,Bacteroidota,Balneolota,Caldisericota,Calditrichota,Chlamydiota,Chlorobiota,Chloroflexota,Chrysiogenota,Coprothermobacterota,Cyanobacteriota,Deferribacterota,Deinococcota,Dictyoglomerota,Elusimicrobiota,Fibrobacterota,Fusobacteriota,Gemmatimonadota,Kiritimatiellota,Lentisphaerota,Mycoplasmatota,Nitrospinota,Nitrospirota,Planctomycetota,Pseudomonadota,Rhodothermota,Spirochaetota,Synergistota,Thermodesulfobacteriota,Thermomicrobiota,Thermotogota,Verrucomicrobiota
- Note: Only valid phyla